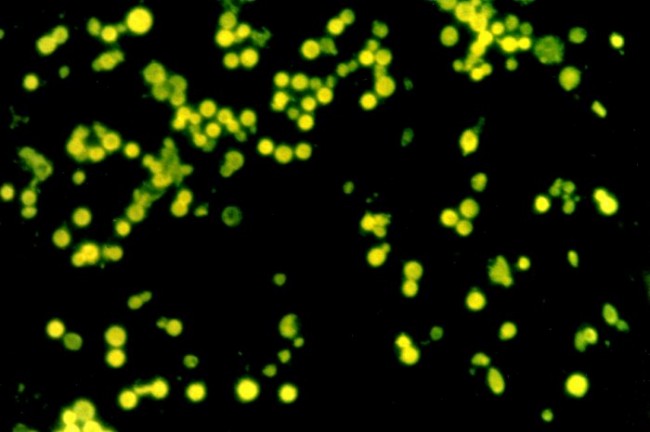
methane

MIT researchers have determined that microbe killers were the source of methane that caused a mass extinction millions of year ago. Tiny organisms known as Methanosarcina bloomed in the oceans about 252 million years ago and gave off a large amount of the poison gas, which changed the atmosphere and the chemical makeup of the oceans.
MIT researchers have determined that microbe killers were the source of methane that caused a mass extinction millions of year ago. Tiny organisms known as Methanosarcina bloomed in the oceans about 252 million years ago and gave off a large amount of the poison gas, which changed the atmosphere and the chemical makeup of the oceans.
The ocean swarm of micro-organisms was the byproduct of volcanic eruptions which threw off the substance nickel. The nickel from the volcanoes provided the metabolic fuel necessary for the bloom to occur. Scientists previously suspected that the volcano eruptions themselves caused the horrific killing, but the MIT researchers determined that the volcanoes alone would not have created enough atmospheric carbon dioxide to cause the mass extinction. The carbon dioxide must have come from another source.
Further research indicated to the scientists that the source of the carbon dioxide was derived from a biological source. The carbon dioxide levels would have receded faster if derived only from the volcanoes. The rich source of nickel available from the volcanos was just the right fuel for the tiny methane producing killing machines to consume the carbon in the ocean floors and proliferate in rapid fashion.
The analysis of genome material provided the necessary clues to the researchers. The Methanosarcina acquired a genetic trait from another microscopic organism which allowed them to quickly produce the poison gas under the right conditions. The vast store of carbon in the oceans together with the volcanic nickel provided the perfect storm of material required for a gigantic methane plume. The tiny organisms followed their genetic programming to reproduce quickly and throw off a massive amount of poison gas.
The mass kill off, known as the Permian extinction, had its roots in the volcanoes of the Siberian Traps. The lava flows were so large they would have covered a land area larger than the United States. The atmosphere remained poisoned for over 100,000 years. The earth did not regenerate diverse life for another 30,000,000 years. The length of time the atmosphere remained poisoned was a clue to the researchers that the volcanoes alone could not have caused the killing catastrophe.
The evidence reviewed does not prove conclusively that the Methanosarcina caused the extinction. The evidence supporting the tiny organisms as the source of the methane serves to discredit other competing theories, such as the Siberan Traps eruptions alone causing the extinction. The microscopic organism-induced kill off is the remaining theory which appears to fit all the available evidence. Further research could conceivably change this view, similar to what seems like ever-changing ideas about the health benefits and risks of drinking coffee. Nevertheless, the researchers are reasonably sure that the Methanosarcina played the most significant role in the extinction.
Further buttressing the researchers’ position is the fact that the volcanic material would have limited other micro-organisms from consuming the ocean carbon stores. The volcanic ash starved the oceans of the necessary oxygen for normal microbe activity. The Methanosarcina could metabolize without the same amount of oxygen otherwise needed by the other microbes. The Methanosarcina would have been crowded out if normal oxygen levels existed.
The methane producing microbe killing machines left a trail of evidence that the MIT researchers have found millions of years later. Sherlock Holmes would be proud of the research team finding the apparent solution to this long time mystery.
By William Costolo
Sources:
MIT News
Huffington Post
CBS News
Discover more from Guardian Liberty Voice
Subscribe to get the latest posts sent to your email.


